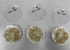

완도해경, 완도 신항만에서 동력수상레저기구 무상점검 서비스 실시 |
이번 행사는 겨울철 장기 보관 후 운항을 재개하는 수상레저기구의 장비 불량 및 고장을 사전에 점검하여 해양 사고를 미연에 방지하고자 마련됐으며, 전문 수리업체(대양마린)과 한국해양교통안전공단(KOMSA) 검사원이 함께 참여하여 항해장비, 엔진, 배터리 등 기구 전반에 대한 무상점검을 지원할 예정이다.
아울러, 출항 전 장비 점검 요령 및 고장 시 응급조치 대응법 교육과 함께 ▲구명조끼 착용 ▲운항 전 기상 확인 및 장비 점검 ▲근거리 수상레저활동 자율 신고 ▲음주운항 등 안전 위해행위 금지 등 안전한 수상레저활동을 위해 반드시 지켜야 할 안전수칙 홍보 캠페인을 함께 진행할 예정이다
완도해경 관계자는 “최근 완도 관내 동력수상레저기구의 기관고장에 의한 표류사고가 증가하고 있어 출항 전 철저한 사전점검 생활화를 당부드린다”며, “안전한 수상레저 활동을 위해 이번 무상점검 서비스에 많은 관심과 참여 부탁드린다”고 전했다.
무상 점검을 희망하는 동력수상레저기구 소유주께서는 완도해양경찰서 교통레저계로 신청이 가능하다.
 박인석 기자 aihnnews@kakao.com
박인석 기자 aihnnews@kakao.com 2026.04.16 (목) 19:12
2026.04.16 (목) 19:12